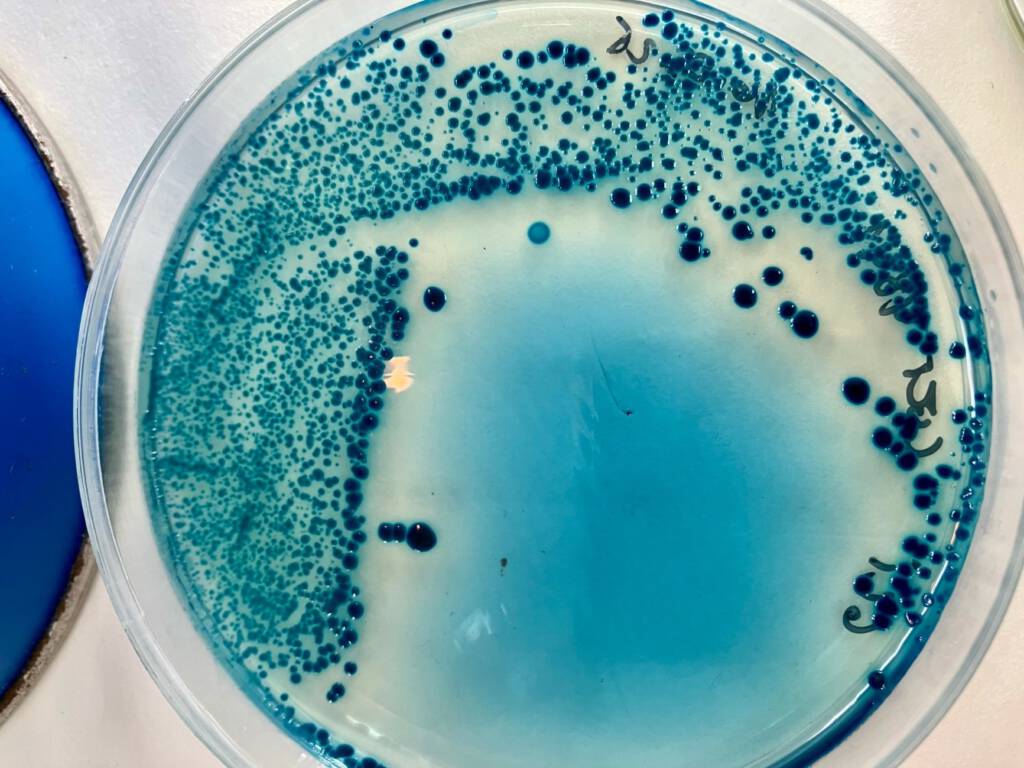

Entomopathogenic Nematodes for Sustainable Pest Control
Discovery of Novel Entomopathogenic Nematodes with Outstanding Insecticidal Properties
Biotechnological Exploration of Photorhabdus and Xenorhabdus bacteria for the development of Next-Generation BioinsecticidesBiotechnological Potential of Biocidal Secondary Metabolites from Photorhabdus and Xenorhabdus
Agricultural systems are increasingly threatened worldwide by insect pests that are not only hard to control but also capable of developing resistance to conventional chemical pesticides. At the same time, the emergence of antibiotic-resistant pathogens presents a growing concern for both plant and animal health. These challenges highlight the urgent need for innovative, sustainable alternatives that go beyond traditional crop protection strategies.
Entomopathogenic nematodes (EPNs), especially those belonging to the genera Steinernema and Heterorhabditis, represent a promising biological tool in this context. These microscopic organisms act in partnership with symbiotic bacteria, Photorhabdus and Xenorhabdus, which contribute significantly to the nematodes’ insect-killing capabilities. Upon infection of an insect host, these bacteria release a complex arsenal of bioactive compounds that rapidly overcome the host’s defenses.
What makes this symbiosis particularly compelling is the remarkable diversity of secondary metabolites produced by these bacteria. Many of these molecules exhibit potent insecticidal, antifungal, and even antibacterial activities, with some of them showing efficacy against antibiotic-resistant strains. This positions EPN-bacteria complexes not only as biological control agents for persistent pest species but also as valuable sources of novel bioactive compounds with potential for and beyond agriculture.
By tapping into the metabolic potential of Photorhabdus and Xenorhabdus, researchers are paving the way for next-generation bioinsecticides and biotechnological applications that align with the principles of sustainability and resistance management.
The research group addresses these challenges through three complementary research lines:
Discovery of Novel Entomopathogenic Nematodes with Outstanding Insecticidal Properties
Identifying new strains of entomopathogenic nematodes (EPNs) adapted to specific ecological niches is crucial for expanding the biological control toolbox. Many native EPN species remain undiscovered, particularly in underexplored habitats with high insect diversity, such as forest soils, grasslands, and agroecological interfaces. Our research focuses on the isolation and characterization of novel Steinernema and Heterorhabditis strains with enhanced infectivity, environmental tolerance, and persistence in soil. Using targeted baiting techniques, molecular tools, and bioassays, we evaluate their virulence profiles against key agricultural pests, including species known to be resistant to chemical insecticides.
These new isolates may possess unique traits—such as improved host-seeking behavior or adaptation to challenging abiotic conditions—that make them valuable candidates for integration into sustainable pest management programs.
Additionally, their association with diverse strains of symbiotic bacteria opens the door to new bioactive compounds with potential applications in pest and disease control.

- Biotechnological Exploration of Photorhabdus and Xenorhabdus Bacteria for the Development of Next-Generation Bioinsecticides
The symbiotic bacteria Photorhabdus and Xenorhabdus play a crucial role in the insecticidal activity of entomopathogenic nematodes by producing a diverse array of pesticidal proteins and bioactive compounds. These natural metabolites constitute a valuable source of new bioinsecticides with potential applications in sustainable pest management.
Through isolating and culturing these bacteria independently, we use genome mining, molecular techniques, proteomics, and insect bioassays to identify and characterize potent pesticidal proteins and secondary metabolites. This research aims to uncover novel compounds with strong and specific insecticidal properties suitable for development as standalone biopesticides.
Moreover, some of these pesticidal proteins have significant potential as transgenes for engineering next-generation insect-resistant crops. When combined in pyramided plants along with genes from Bacillus thuringiensis, they can provide enhanced pest control efficacy and help delay the development of resistance in target insect populations, offering a promising strategy for durable crop protection.
- Biotechnological Potential of Biocidal Secondary Metabolites from Photorhabdus and Xenorhabdus
Beyond their role in insect pathogenesis, the secondary metabolites produced by Photorhabdus and Xenorhabdus exhibit a wide range of biological activities. Many of these compounds possess antimicrobial, antifungal, cytotoxic, and immunosuppressive properties, making them promising candidates for applications in agriculture, medicine, and industry.
Our work explores the diversity, structure, and function of these metabolites, with a particular interest in those capable of overcoming resistance mechanisms in pests and pathogens. Some metabolites have shown strong activity against bacteria that are resistant to conventional antibiotics, highlighting their potential in addressing one of the most pressing challenges in global health.
By combining analytical chemistry, omics technologies, and functional assays, we aim to catalog and evaluate these compounds for their potential as novel biopesticides or antimicrobial agents.
This line of research not only contributes to sustainable agriculture but also positions Photorhabdus and Xenorhabdus as valuable biofactories for the discovery of new natural products with cross-sector impact. In close collaboration with Hospital La Fe, we explore the clinical applications of these compounds, strengthening the bridge between agricultural biotechnology and human health.

Leaders
Selected publications
Genome sequence analysis of native Xenorhabdus strains isolated from entomopathogenic nematodes in Argentina
Palma L, Frizzo L, Kaiser S, Berry C, Caballero P, Bode HB, Del Valle EE. 2024. Toxins. 16:108.
Is the insect world overcoming the efficacy of Bacillus thuringiensis?
Peralta C, Palma L*. 2017. Toxins MDPI. 9:1, 1-5.
Biological control of Diloboderus abderus (Coleoptera: Scarabaeidae) larvae using Steinernema rarum CUL (Nematoda: Steinernematidae) and Heterorhabditis bacteriophora SMC (Nematoda: Heterorhabditidae)
Del Valle E, Frizzo LS, Lax P, Bonora JS, Palma L, Bernardi-Desch PN, Pietrobo M, Doucet ME. 2017. Crop. Prot. 98, 184-190. https://doi.org/10.1016/j.cropro.2017.04.004
Draft genome sequence of Photorhabdus luminescens strain DSPV002N isolated from Santa Fe, Argentina
Palma L, Eleodoro E. Del Valle, Laureano Frizzo, Colin Berry, Primitivo Caballero. 2016. Genome Announc. 4:4, e00744-16.

